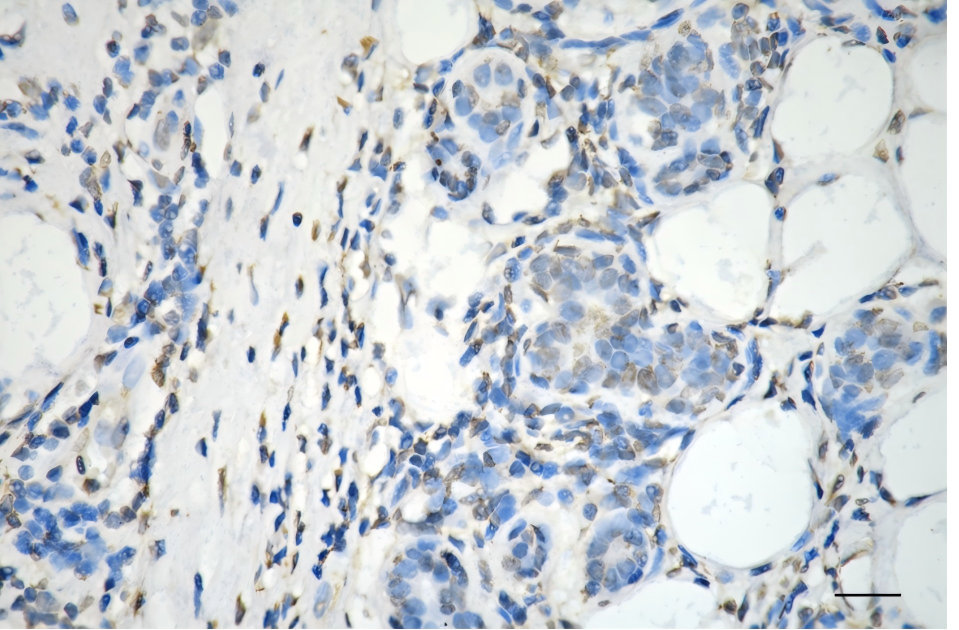

TGM2 Monoclonal Antibody
-
中文名稱:TGM2 Monoclonal Antibody
-
貨號:CSB-MA437755
-
規格:¥1320
-
圖片:
-
Flow cytometric analysis of Transglutaminase 2 expression in HT-1080 cells using Transglutaminase 2 antibody. Green, isotype control; red, Transglutaminase 2.
-
Immunohistochemistry was performed on paraffin-embedded human breast carcinoma using transglutaminase 2 antibody. Antigen retrieval was done in sodium citrate buffer (pH 6.0). DAB was used for detection, with hematoxylin counterstaining. Images were acquired using a Nikon Ci-L Plus microscope (40× objective). Scale bar: 25 μm.
-
Western blotting analysis using transglutaminase 2 antibody. Total cell lysates (30 μg) from various cell lines were loaded and separated by SDS-PAGE. The blot was incubated with transglutaminase 2 antibody and HRP-conjugated goat anti-mouse secondary antibody respectively.
-
-
其他:
產品詳情
-
產品名稱:Mouse anti-Homo sapiens (Human) TGM2 Monoclonal antibody
-
Uniprot No.:
-
基因名:
-
別名:TGM2; Transglutaminase 2; TGC; C Polypeptide, Protein-Glutamine-Gamma-Glutamyltransferase; Protein-Glutamine Noradrenalinyltransferase TGM2; Protein-Glutamine Gamma-Glutamyltransferase 2; Protein-Glutamine Histaminyltransferase TGM2; Protein-Glutamine Dopaminyltransferase TGM2; Protein-Glutamine Serotonyltransferase TGM2; Protein-Glutamine Deamidase TGM2; Erythrocyte Transglutaminase; Tissue Transglutaminase; Transglutaminase II; Protein G Alpha(H); Transglutaminase C; Transglutaminase H; Isopeptidase TGM2; Heart G Alpha(H); HhG Alpha(H); EC 2.3.2.13; TGase II; TGase C; TGase H; TGase-2; TTgase; TG(C); G(H); HTG2; TG2; TTG; Transglutaminase 2 (C Polypeptide, Protein-Glutamine-Gamma-Glutamyltransferase); Transglutaminase-2; EC 3.5.1.44; EC 3.4.-.-; EC 2.3.1.-
-
宿主:Mouse
-
反應種屬:Human
-
免疫原:Recombinant Human TGM2 protein
-
免疫原種屬:Homo sapiens (Human)
-
標記方式:Non-conjugated
-
克隆類型:Monoclonal
-
抗體亞型:Mouse IgG1
-
純化方式:Affinity-chromatography
-
克隆號:25D8
-
濃度:It differs from different batches. Please contact us to confirm it.
-
保存緩沖液:PBS (pH 7.4) containing 50% glycerol, and 0.02% sodium azide.
-
產品提供形式:Liquid
-
應用范圍:ELISA, WB, FC, IHC
-
推薦稀釋比:
Application Recommended Dilution WB 1:400-1:2000 FC 1:200-1:2000 IHC 1:100-1:200 -
Protocols:
-
儲存條件:Upon receipt, store at -20°C or -80°C. Avoid repeated freeze.
-
貨期:Basically, we can dispatch the products out in 1-3 working days after receiving your orders. Delivery time maybe differs from different purchasing way or location, please kindly consult your local distributors for specific delivery time.
-
用途:For Research Use Only. Not for use in diagnostic or therapeutic procedures.
相關產品
靶點詳情
-
功能:Calcium-dependent acyltransferase that catalyzes the formation of covalent bonds between peptide-bound glutamine and various primary amines, such as gamma-amino group of peptide-bound lysine, or mono- and polyamines, thereby producing cross-linked or aminated proteins, respectively. Involved in many biological processes, such as bone development, angiogenesis, wound healing, cellular differentiation, chromatin modification and apoptosis. Acts as a protein-glutamine gamma-glutamyltransferase by mediating the cross-linking of proteins, such as ACO2, HSPB6, FN1, HMGB1, RAP1GDS1, SLC25A4/ANT1, SPP1 and WDR54. Under physiological conditions, the protein cross-linking activity is inhibited by GTP; inhibition is relieved by Ca(2+) in response to various stresses. When secreted, catalyzes cross-linking of proteins of the extracellular matrix, such as FN1 and SPP1 resulting in the formation of scaffolds. Plays a key role during apoptosis, both by (1) promoting the cross-linking of cytoskeletal proteins resulting in condensation of the cytoplasm, and by (2) mediating cross-linking proteins of the extracellular matrix, resulting in the irreversible formation of scaffolds that stabilize the integrity of the dying cells before their clearance by phagocytosis, thereby preventing the leakage of harmful intracellular components. In addition to protein cross-linking, can use different monoamine substrates to catalyze a vast array of protein post-translational modifications: mediates aminylation of serotonin, dopamine, noradrenaline or histamine into glutamine residues of target proteins to generate protein serotonylation, dopaminylation, noradrenalinylation or histaminylation, respectively. Mediates protein serotonylation of small GTPases during activation and aggregation of platelets, leading to constitutive activation of these GTPases. Plays a key role in chromatin organization by mediating serotonylation and dopaminylation of histone H3. Catalyzes serotonylation of 'Gln-5' of histone H3 (H3Q5ser) during serotonergic neuron differentiation, thereby facilitating transcription. Acts as a mediator of neurotransmission-independent role of nuclear dopamine in ventral tegmental area (VTA) neurons: catalyzes dopaminylation of 'Gln-5' of histone H3 (H3Q5dop), thereby regulating relapse-related transcriptional plasticity in the reward system. Regulates vein remodeling by mediating serotonylation and subsequent inactivation of ATP2A2/SERCA2. Also acts as a protein deamidase by mediating the side chain deamidation of specific glutamine residues of proteins to glutamate. Catalyzes specific deamidation of protein gliadin, a component of wheat gluten in the diet. May also act as an isopeptidase cleaving the previously formed cross-links. Also able to participate in signaling pathways independently of its acyltransferase activity: acts as a signal transducer in alpha-1 adrenergic receptor-mediated stimulation of phospholipase C-delta (PLCD) activity and is required for coupling alpha-1 adrenergic agonists to the stimulation of phosphoinositide lipid metabolism.; Has cytotoxic activity: is able to induce apoptosis independently of its acyltransferase activity.
-
基因功能參考文獻:
- Data suggest that disulfide bond switch in allosteric activation/inactivation of TGM2 is example of post-translational redox regulation that is reversibly and allosterically modulated by two proteins (ERp57 and TRX). (TGM2 = transglutaminase 2; ERp57 = endoplasmic reticulum resident protein 57; TRX = thioredoxin-1) PMID: 29305423
- This suggests that TGase 2 has an allosteric binding site (81-116 a.a) which changes the conformation of TGase 2 enough to accelerate inactivation through self-polymer formation. PMID: 30105541
- Taken together, the present data suggested a potentially important role for TGM2 in the regulation of osteosarcoma chemosensitivity. TGM2 might therefore serve as a therapeutic target for osteosarcoma. PMID: 30015899
- Multiple symptoms and high serum anti-tTG antibody levels correlated with mucosal damage in children with Celiac disease. PMID: 30016777
- Production of anti-TG2 antibodies could be due to a general state of inflammation or could indicate a very early stage of a gluten-dependent pathology. PMID: 28934109
- A long non-coding RNA is located within the first intron of transglutaminase 2 gene. LOC107987281 lncRNA is induced when levels of TGM2 transcripts are also increased, for example after drug treatment. In addition, correlation analysis between the expression of this lncRNA and TGM2 demonstrated that occurs in relation to the development of several tumors affecting pancreas, stomach and kidney. PMID: 29313085
- TG2 plays a crucial role in the proliferative process PMID: 27591334
- The results point to regulation of alternative splicing of tissue transglutaminase could account for the complex physiopathology of celiac disease. PMID: 29543397
- Our data revealed that patients with lower level of TG2 expression detected in cancer tissues had longer disease free survival and overall survival as compared to the patients with higher TG2 expression. PMID: 28715877
- Gluten-free diet compliance and lower antitissue transglutaminase (atTG) at diagnosis are predictors of earlier normalization of atTG levels in patients with celiac disease. Patients with type 1 diabetes mellitus are less likely to normalize atTG levels, with longer normalization time. PMID: 27906802
- expression in psoriasis was higher than in normal skin PMID: 28150335
- Serum tissue transglutaminase antibody was elevated in almost one-quarter of an eosinophilic esophagitis (EoE) cohort, and at least 20% of these patients did not have potential celiac disease, suggesting EoE is a heterogeneous disease with differing immune mechanisms activated in some patients. PMID: 28644352
- Study indicates that TGM2 affects the metastatic potential and stemness of colorectal cancer stem cells by regulating EMT- and stemness-related proteins. PMID: 29374703
- PARP3 controls of TGFbeta-induced epithelial mesenchymal transformation and acquisition of stem-like cell features by stimulation transglutaminase 2/SNAI1 signaling. PMID: 27579892
- Circulating tissue transglutaminase is associated with sFlt-1, soluble endoglin and VEGF in the maternal circulation of preeclampsia patients, suggesting that tTG may have a role in the pathogenesis of PE. PMID: 27169826
- 19% of pediatric celiac disease patients treated with a gluten-free diet had persistent enteropathy. At the time of the repeat biopsy, tTG was elevated in 43% of cases with persistent enteropathy and 32% of cases in which there was mucosal recovery. Overall the positive predictive value of the autoantibody tTG was 25% and the negative predictive value was 83% in patients on a gluten-free diet for a median of 2.4 years. PMID: 28112686
- Computational analyses of the effect of novel amino acid clusters of human transglutaminase 2 on its structure and function have been presented. PMID: 27627884
- The link is being discussed between P2X7R signaling and TG2 export, a pathway that has been recently discovered and tied extracellular protein modifications into the danger signal-mediated innate immune response. (Review) PMID: 27562793
- TG2-regulated signaling bestows on cancer cells the ability to proliferate, to resist cell death, to invade, to reprogram glucose metabolism and to metastasize, making it a therapeutic target. (Review) PMID: 27562794
- TGM2 is involved in the resistance of cancer cells to the histone deacetylase inhibitor vorinostat. PMID: 27761756
- TGM2 is involved in amyloid-beta (1-42)-induced pro-inflammatory activation via AP1/JNK signaling pathways in cultured monocytes. PMID: 27864692
- The role of TG2 in certain pathological conditions, in which inflammation and monocytes and/or macrophages are prominently present, including atherosclerosis, sepsis, and multiple sclerosis, has been discussed. (Review) PMID: 27659795
- The 45 kDa gelatin-binding domain of fibronectin is responsible for the binding to TGM2. PMID: 27394141
- Inter-molecular crosslinking activity is engendered by the dimeric form of transglutaminase 2. PMID: 27394142
- Transglutaminase type 2 affects cell migration through post-translational modification of PDGF-BB. PMID: 27633721
- An increased chondrocyte TGM2 expression characterized human osteoarthritis cartilage degeneration, but not trabecular bone tissue remodeling independently from the cause. PMID: 27357308
- High TGM2 expression is associated with recurrence in Glioma. PMID: 28754668
- Exosomes from cells lacking TG2 present less protein content. Proteasome inhibition leads to the selective recruitment of TG2 in the exosomes. TG2 is an important player in the biogenesis of exosomes controlling the selectivity of their cargo under stressful cellular conditions. PMID: 27169926
- High transglutaminase 2 expression is associated with colorectal cancer. PMID: 28223538
- GTP binding, but not transamidase activity, is required for TG2-dependent cancer stem cell invasion, migration and tumour formation. However, transamidase site-specific inhibitors reduce cancer stem cell survival. PMID: 27941875
- these findings ascribe a novel function for ALDH1A3 in an aggressive glioma stem cells phenotype via the up-regulation of tissue transglutaminase PMID: 28423611
- Data show that carboxyl-terminus of Hsp70-interacting protein (CHIP) promotes polyubiquitination of transglutaminase 2 (TG2) and its subsequent proteasomal degradation. PMID: 26568304
- No clear evidence for an association of tTGA or EMA seropositivity with incident coronary heart disease outcomes, suggesting that tTG autoimmunity is unlikely to be the biological link between coeliac disease and CHD. PMID: 28756971
- the TG2 enzymatic activity was negligibly affected by bexarotene treatment. It is important to control TG2 overexpression since its upregulation is correlated with tumor transformation and drug resistance. Bexarotene also showed in vivo tumoricidal effects in a GBM xenograft mouse model. Therefore, we suggest bexarotene as a more beneficial differentiation agent than ATRA for GBM. PMID: 26957434
- Thus it can be concluded that human transglutaminases differ in harboring damaging variants and TGM2 is under purifying selection suggesting that it may have so far not revealed physiological functions. PMID: 28248968
- mechanical load-induced TGM2 expression and enzyme activity is involved in the progression of the calcification of ligamentum flavum. PMID: 27115725
- interconnected network of TG2/NF-kappaB and IL6/STAT3 signaling with autophagy regulation in MCL cells. PMID: 27488529
- TGM2 expression was not significantly correlated with ovarian cancer antineoplastic drug resistance. PMID: 27669502
- The serum level of TG2 is increased in patients with chronic spontaneous urticarial, and TG2 is expressed in mast cells in the lesional skin of these patients. PMID: 27613463
- these findings suggest that constitutive TG2 expression results in stabilization of DeltaNp63alpha, leading to maintenance of epidermal squamous cell carcinoma cancer stem cell properties and enhanced tumor formation PMID: 27780825
- TGM2 has a role in macrophage differentiation via mechanisms involving CD14 and SR-AI receptors. TGM2 inhibition triggers a pro-inflammatory phenotype. PMID: 27378395
- The mRNA level of EMT-related genes was highly positively correlated with TGM2 mRNA. TGM2 might contribute to early hepatocellular carcinoma (HCC)recurrence through signaling pathways not related to EMT and integrin signaling PMID: 28339069
- C-terminal truncation of transglutaminase 2 (TG2) reduces binding to the small intestinal extracellular matrix (ECM) despite retained fibronectin (FN)-binding capacity. PMID: 27685605
- Ablation of transglutaminase 2 impairs astrocyte migration subsequent to injury. Astrocyte migration can only be restored with catalytically active transglutaminase 2. PMID: 27899316
- findings support the potential pathophysiological relevance of TRX in celiac disease and establish the Cys(370)-Cys(371) disulfide bond of TG2 as one of clearest examples of an allosteric disulfide bond in mammals. PMID: 28003361
- TG2 has another role in cystic fibrosis pathology linked with TGFbeta1 activation and signaling. PMID: 27234323
- the ability of epitope 1-targeting B cells to keep TG2 active and protected from oxidation might explain why generation of epitope 1-targeting plasma cells seems to be favored in celiac patients. PMID: 27784785
- TGM2 levels in sputum and plasma were elevated in patients with moderate to severe chronic obstructive pulmonary disease, and correlated with lung function. PMID: 27084846
- our results demonstrate that TG2 secreted in the pancreatic TME orchestrates the cross talk between cancer cells and stroma, impacting tumor growth and response to chemotherapy. PMID: 27792935
- TTG is an excellent screening test for the diagnosis of paediatric CD. TTG value > 50 IU/ml has 100% positive predictive value. PMID: 27097694
顯示更多
收起更多
-
亞細胞定位:Cytoplasm, cytosol. Nucleus. Chromosome. Secreted, extracellular space, extracellular matrix. Cell membrane. Mitochondrion.; [Isoform 2]: Cytoplasm, perinuclear region.
-
蛋白家族:Transglutaminase superfamily, Transglutaminase family
-
數據庫鏈接:
Most popular with customers
-
-
Phospho-YAP1 (S127) Recombinant Monoclonal Antibody
Applications: ELISA, WB, IHC
Species Reactivity: Human
-
-
-
-
-
-